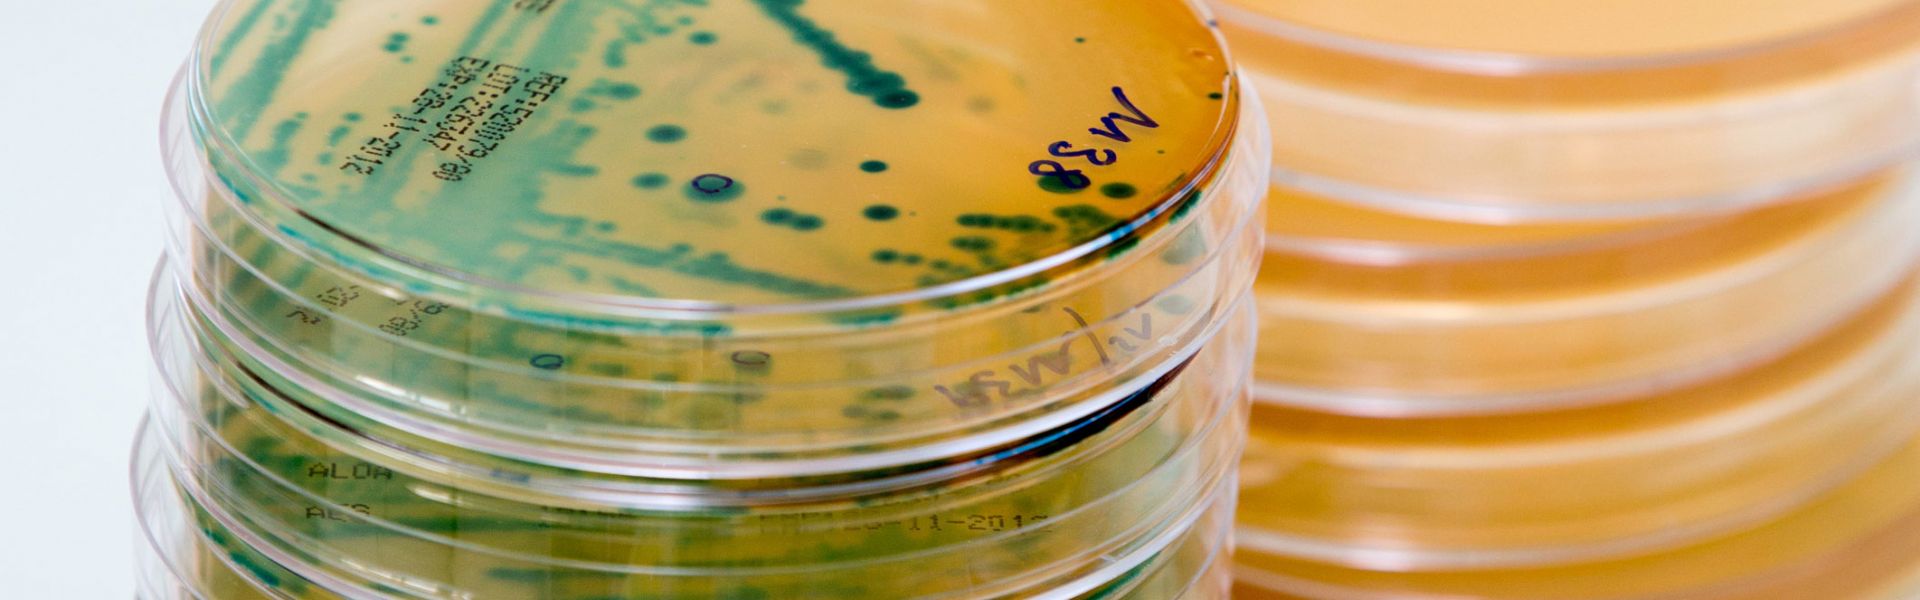

Laboratoire de sécurité des aliments, sites de Maisons-Alfort et de Boulogne-sur-Mer
Directeur : Laurent Laloux
Directeur adjoint scientifique : Jacques-Antoine Hennekinne
Directrice adjointe chargée des affaires générales : Catherine Lambert
Adresses :
Maisons-Alfort : 14 rue Pierre & Marie Curie 94701 Maisons-Alfort Cedex - Tél : 01 49 77 13 50
Boulogne-sur-Mer : 6 boulevard Bassin Napoléon 62200 Boulogne-sur-Mer - Tél : 03 21 99 25 00
Email : contact.LSAL@anses.fr
Effectif : environ 140 personnes réparties au sein de 10 unités et une plateforme technologique
Le laboratoire de sécurité des aliments s’intéresse aux dangers biologiques et chimiques qui peuvent affecter la sécurité sanitaire et la qualité des aliments. Il est implanté sur deux sites, à Maisons-Alfort et à Boulogne-sur-Mer.
La "sécurité des aliments" ou "sécurité sanitaire des aliments" est la garantie de l'innocuité des produits alimentaires, c'est-à-dire que leur consommation n'aura pas de conséquences néfastes sur la santé. Les activités scientifiques du laboratoire visent à enrichir la connaissance de la nature des contaminants ou « dangers » présents dans les aliments, à comprendre leur mode d'action et leurs répercussions sur la santé et enfin à contribuer à une meilleure politique de prévention de la santé des consommateurs.
Le site de Maisons-Alfort réunit 120 personnes, spécialisées en sécurité sanitaire des aliments et celui de Boulogne-sur-Mer plus de 20 personnes, qui se consacrent exclusivement aux produits de la pêche et de l'aquaculture.
Les missions du laboratoire
Le laboratoire de sécurité des aliments apporte une expertise scientifique aux décideurs publics, à la fois généraliste sur la qualité et la sécurité sanitaire des denrées alimentaires, mais aussi plus spécifique, sur certaines filières de transformation.
Le laboratoire concentre ses travaux sur les dangers biologiques (bactéries, virus, parasites) et chimiques (toxines, éléments traces métalliques, pesticides, polluants organiques, histamine) présents ou susceptibles d’être présents dans les aliments, et tout particulièrement au stade de leur distribution et de leur consommation :
- il développe des connaissances sur l'identification des dangers dans les aliments ;
- il développe des méthodes pour les détecter, les caractériser et les quantifier ;
- il analyse leur cause d'apparition et leurs facteurs de développement ;
- il contribue à leur surveillance, notamment pour signaler l’émergence ou la réémergence de certains organismes ou molécules ;
- il contribue à la normalisation et à l’élaboration de la réglementation pour les méthodes et critères propres à ces dangers ;
- il contribue à l'évaluation des risques qui leurs sont associés, notamment en contribuant à des analyses quantitatives de risque et en apportant des données de prévalence d'un danger biologique ou d’occurrence d’un danger chimique ;
- il étudie l'influence des pratiques et procédés sur l'expression des dangers alimentaires et se focalise en particulier sur l'efficacité des moyens de maîtrise mis en œuvre tout au long de la vie d’un aliment (de la fourche à la fourchette) et sur les indicateurs de qualité relatifs à l’hygiène.
Le laboratoire réalise également des prestations analytiques pour les autorités sanitaires et les professionnels sur les produits de la pêche (poissons, coquillages, crustacés) à Boulogne-sur-Mer et sur toutes denrées alimentaires à Maisons-Alfort, dans le cadre du Laboratoire central des services vétérinaires ,qui réalise des analyses officielles pour les Directions départementales de la protection des populations (DDPP) pour la région parisienne.
Le laboratoire héberge la plate-forme nationale technologique « IdentyPath », pour l’identification et le typage des agents pathogènes par PCR haut et moyen débit.
Principaux contaminants biologiques étudiés :
- Salmonella ;
- E. coli pathogènes ;
- staphylocoques à coagulase positive ;
- Listeria monocytogenes ;
- Bacillus cereus ;
- les vibrions ;
- les Clostridiums ;
- les virus entériques (VHA, VHE, norovirus, entérovirus) ;
- les parasites des poissons en particulier les Anisakidae.
Principaux contaminants chimiques étudiés :
- pesticides (organochlorés, organophosphorés, pyréthrinoïdes, carbamates…) ;
- éléments traces métalliques (plomb, mercure, cadmium, cuivre, ...), non métalliques (arsenic, sélénium, …), les nanomatériaux et minéraux (sodium, potassium, calcium, magnésium…) ;
- toxines bactériennes (toxines de Staphylococcus aureus et de Bacillus cereus) ;
- biotoxines marines (toxines lipophiles, acide domoïque, saxitoxines, pinnatoxines, ciguatoxines...) ;
- cyanotoxines (microcystines…) ;
- amines biogènes (histamine, cadavérine, putrescine…) ;
- nano et micro-plastiques.
En savoir plus sur le laboratoire
>> Consulter la plaquette (PDF)
>> Consulter le rapport d'activité (PDF)
Dernière actualité du labo

Les capsules des bouteilles en verre contaminent les boissons avec des microplastiques
Il y a des microplastiques dans toutes les boissons mais celles dans des bouteilles en verre en contiennent plus que dans des bouteilles en plastique, des briques ou des canettes. C’est étonnamment ce que révèle une étude menée par l’unité à Boulogne-sur-Mer du Laboratoire de sécurité des aliments de l’Anses. L’hypothèse investiguée par les scientifiques est que ces particules de plastiques viennent des peintures des capsules des bouteilles. L’eau et le vin sont moins concernés que les autres boissons. Ces résultats permettent d’identifier une source de présence de microplastiques dans les boissons contre laquelle les industriels peuvent facilement prendre des mesures.
Les unités du laboratoire
Le laboratoire comprend 10 unités et une plateforme technologique, trois missions et six services d’appui répartis sur deux sites, Maisons-Alfort et Boulogne-sur-Mer:
- Unité Biochimie des produits aquatiques (BPA), sous contrat avec l’université du littoral côte d’opale
- Unité E. Coli pathogènes (Colipath)
- Unité Éléments traces et nanomatériaux (ETNA)
- Plateforme nationale d’identification et de typage des agents pathogènes (IdentyPath)
- Unité laboratoire central des services vétérinaires (LCSV)
- Unité Pesticides et biotoxines marines (PBM)
- Unité Sécurité sanitaire des aliments d’origine aquatique (SANAQUA)
- Unité Staphylococcus, Bacillus, Clostridium (SBCL)
- Unité Salmonella et Listeria (SEL)
- Unité virus entériques (VE)
Les partenariats
Les partenariats scientifiques sont une forte priorité pour le laboratoire, avec pour objectif principal de rechercher des complémentarités de compétences et d’approche analytique auprès de partenaires extérieurs.
Dans ce cadre, des structurations durables de partenariat au niveau régional ont été nouées, notamment avec les universités, l'Ulco (université littoral côte d’Opale) en région Haut de France et l'Upec (université Paris-est Créteil), en Ile de France. Des structurations sous forme de SFR (Structure fédératrice de recherche) ou d’EUR (École universitaire de recherche) sont envisagés avec ces partenaires.
À l’international, le laboratoire s’inscrit dans les partenariats stratégiques de l’Anses ou de l’État français, avec différentes agences européennes, notamment les collaborations avec nos homologues du Federal Institute for Risk Assessment en Allemagne, de la Technical University of Denmark , de Sciensano en Belgique et du Central Public Health Institute (ISS), en Italie. Hors de l’Europe, un accent est porté sur les collaborations avec les grands organismes d’Amérique du Nord (Etats-unis, Canada) et un rapprochement partenarial avec l’Inde, la Chine et l’Asie du Sud-Est est étudié.
Partenariats nationaux
- Actia (Association des centres techniques agro-industriels), Acta (Association des centres techniques agricoles)
- Centres hospitaliers universitaires
- Centres techniques de l’agroalimentaire
- Centre national de la recherche scientifique (Cnrs)
- Commissariat à l'énergie atomique et aux énergies alternatives (CEA)
- Conseil régional des Hauts-de-France
- Conseil régional d’Île-de-France
- Directions départementales de la protection des populations
- Écoles agronomiques (Agroparistech)
- Écoles vétérinaires
- Fédérations professionnelles
- Institut français de recherche pour l’exploitation de la mer (Ifremer)
- Institut national de recherche pour l'agriculture, l'alimentation et l'environnement (Inrae)
- Institut Pasteur de Paris et de Lille
- Laboratoire national de métrologie et d’essais (LNE)
- Ministère de l’Agriculture et de l'alimentation (Direction générale de l’alimentation)
- Ministère des Solidarités et de la santé (Direction générale de la santé),
- Muséum national d’Histoire naturelle
- Pôle de compétitivité Aquimer
- Santé publique France (SPF)
- Service commun des laboratoires (SCL)
- Universités (Paris-Est Sup, Paris Saclay, Lille Nord de France, du littoral côte d’opale…)
Partenariats internationaux
- Agence de la santé publique du Canada
- Agence canadienne d'inspection des aliments
- Autorité européenne de sécurité alimentaire (Efsa)
- Centers for Disease Control and Prevention (CDC, ECDC)
- Istituto Superiore di Sanità (ISS, Italie)
- Comité européen de normalisation (CEN)
- Commission européenne (DG Santé)
- Federal Institute for Risk Assessment (BfR, Allemagne)
- Finnish Food Safety Agency (EVIRA, Finlande)
- Istituto Zooprofilattico Sperimentale (Italie)
- Centre commun de recherche européen (Geel Belgique et Ispra Italie)
- National Institute for Public Health and the Environment (RIVM, Pays-Bas)
- National Institute of Standards and Technology (NIST, USA)
- National Veterinary Institute (SVA, Suède)
- Organisation internationale de normalisation (ISO)
- Public Health England (PHE Angleterre)
- Réseaux des laboratoires nationaux de référence des pays européens
- Technical University of Denmark (DTU, Danemark)
- Université d'Oviedo (Espagne)
- Veterinary Laboratories Agency (VLA, Angleterre)
Les prestations du laboratoire
Prestations analytiques
Adresses et horaires de livraisons des échantillons :
Site de Boulogne-sur-Mer
Horaires : 9:00 - 12:30 / 14:00 - 17:00
6 Boulevard Bassin Napoléon, 62200 Boulogne sur mer
Site de Maisons-Alfort
Horaires : 9:00 - 16:30
14 rue Pierre et Marie Curie, 94701 Maisons-Alfort Cedex
Les prestations d'analyse du laboratoire de Sécurité des Aliments et leurs conditions de réalisation sont répertoriées dans le catalogue des prestations propre au laboratoire. Vous pouvez également consulter les tarifs et les conditions générales de vente.
Les unités du laboratoire de sécurité des aliments, dotées d'un logiciel de gestion des analyses, proposent de transmettre les rapports d’analyses par voie électronique, en lieu et place de l'envoi par voie postale, afin de réduire les délais d’envoi et de vous faciliter leur transmission. Pour pouvoir bénéficier de ce service, merci de bien vouloir nous retourner signée la convention de preuve.
Le laboratoire est accrédité par le Cofrac selon la norme NF EN ISO/CEI 17025 sous le numéro 1-7341 pour les essais définis dans la portée d’accréditation (disponible sur le site du Cofrac). L’utilisation de la marque d’accréditation du laboratoire par les clients et parties prenantes n’est pas autorisée en dehors des documents émis par le laboratoire sous leur forme intégrale (ex : rapports d’analyses).
Organisation des essais interlaboratoires d'aptitude
Les essais interlaboratoires d'aptitude organisés par le laboratoire de Sécurité des aliments et les conditions d’inscription sont accessibles sur le logiciel LEILA.
Le laboratoire (site de Maisons-Alfort) est accrédité par le Cofrac selon la norme NF EN ISO/CEI 17043 sous le numéro 1-6993 pour l’organisation des essais interlaboratoires d’aptitude définis dans la portée d’accréditation (disponible sur le site du Cofrac ) et dans la portée d’accréditation détaillée. L’utilisation de la marque d’accréditation du laboratoire par les clients et parties prenantes n’est pas autorisée en dehors des documents émis par le laboratoire sous leur forme intégrale (ex : rapports d’essais interlaboratoires d’aptitude).
Réclamations
L’expression d’insatisfaction (réclamation) doit être formulée par écrit (mail ou courrier) auprès du responsable de l’activité concerné (ex : signataire des analyses, coordonnateur de l’EIL, etc.) ou du service qualité (cecile.cecconi@anses.fr). Le processus de traitement des réclamations est disponible sur demande auprès du service qualité.







